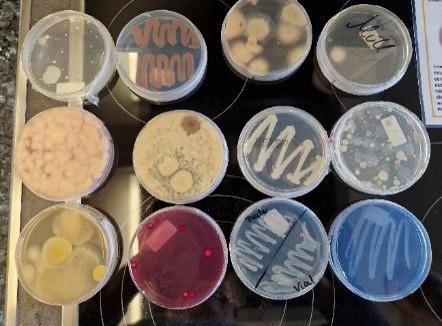

Auch in diesem Jahr durften wir wieder Vertreterinnen der Firma Bauer im Fachbereich Ernährung und Soziales, in den 8. Klassen begrüßen.
Fr. Simmeth aus der Personalabteilung wurde von Kolleginnen aus Produktion und Labor begleitet.
Die Schülerinnen und Schüler erfuhren welche wichtige Rolle Hygiene und Sicherheit in der Herstellung von Milchprodukten spielt und wurden über einzelne Produktionsabläufe informiert.

Auch die Sensorik kam nicht zu kurz. So konnten die Schüler ihre Sinne auf Geruch und Farbe testen. Es war gar nicht so einfach, immer die richtigen Duftnoten zuzuordnen.
Die Schulung der Sensorik dient dazu, Farbstandards festzulegen und die Geruchsnerven zu sensibilisieren. Diese Sensibilisierung ist sehr wichtig, da sie täglich bei der Produktüberprüfung eingesetzt wird.

Auch so genannte „Abklatschproben“ wurden genau unter die Lupe genommen, wobei so mancher Schimmelpilz einem kleinen Kunstwerk gleichkam.



Nach einem sehr umfangreichen Firmenportrait durften sie an Stationen Naturjoghurts mit verschiedenen Fruchtzubereitungen selbst anmischen. Bei den Geschmacksproben des umfangreichen Sortiments der Firma Bauer fand jeder schnell seinen Favoriten.

Mit kleinen Tests, wie z. B. dem Pipettieren der Milch oder ph-Wert-Messungen wurde unter fachkundiger Anleitung ein kleiner Einblick in das Aufgabenfeld der Laborarbeit ermöglicht.

Bei einem abschließenden Video über die Firma Bauer zeigte sich nochmals, wie vielseitig das Berufsangebot des Betriebes ist.
Mit vielen tollen Informationen und Geschenken der Firma Bauer endete der sehr kurzweilige Besuch.
Wir bedanken uns ganz herzlich und hoffen auf einen weiteren Besuch im nächsten Jahr.
STEFANIE HINTERSTOCKER (Fachoberlehrerin EG